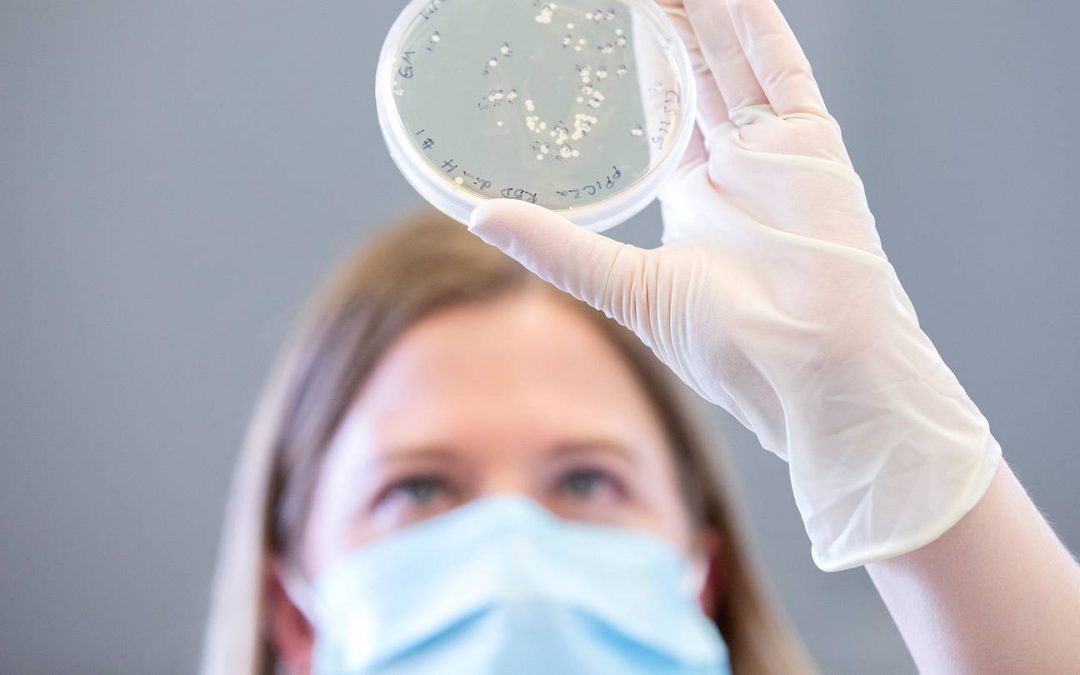
Here’s to the heroes of 2020 – and a better 2021

by Bruce Cotterill | Dec 19, 2020 | Uncategorised
Most people I speak to can’t wait for 2020 to end. Businesspeople in particular seem keen to move on in the hope that 2021 might be a better year. Of course, there is still plenty of uncertainty about what the next couple of years may bring. But for now, it...

by Bruce Cotterill | Dec 5, 2020 | Uncategorised
Do you remember George Burns? He was a wonderful American comedian who was still performing live in the 1990’s, complete with a cigar in one hand and a quick wit, at the age of 101. I once saw him speaking about his experience as an actor. He said, “acting...

Recent Comments